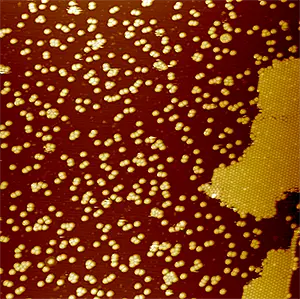

Spinterfaces: Interfaces for Organic Spintronics
Spinterfaces: Interfaces for Organic Spintronics
Spintronics (short for spin- electronics) is a science that aims to extend classical electronics by storing and manipulating the transported information through the carrier's spin polarization rather than through its charge.
While spintronics approaches are commonly based on ordinary inorganic semiconductors, a parallel, innovative approach considers the possibility of exploiting organic semiconductors. The latter are, in particular, well suited for transport of spin polarization due to a lower spin-scattering rate than for inorganic semiconductors. Spin can be thus injected from ferromagnetic metals into organic semiconductors, where it can travel relatively long distances.
A fascinating aspect of organic spintronics is the understanding of the hybridization between the ferromagnetic metal and the organic layers at interfaces: the so-called “spinterfaces”.
The thesis project is aimed to investigating such aspects from a fundamental experimental point of view, combining both information on how the spinterfaces are formed and on the hybridization of the interfacial electronic states.
The main part of the project will be conducted in the Scanning Tunneling Microscopy (STM) laboratory. STM will allow the experimenters to visualize the early stages of interface formation (Figure 1): such results will be combined with Scanning Tunneling Spectroscopy (STS) to derive atomic-scale information on the materials electronic structure and to other chemical/structural tools, to have an overall view of the interface properties. Many different organic materials will be considered in the project, ranging from the well known and characterized C60 fullerene to metal porphirines and phtalocyanines.
During the project, collaboration with our Electron Spectroscopy laboratory will allow us to get into more details concerning the interface electronic properties (Figure 2) and to add the information that can come from magnetic resolved experiments to the physical understanding of the spinterface system.
Figure 1 STM image (80 x 80 nm2) of the early stages of C60 fullerene growth on the oxidized Fe surface.
Figure 2 Ultraviolet Photoemission Spectroscopy of the sample presented in Fig. 1, as a function of the C60 coverage
01/02

02/02